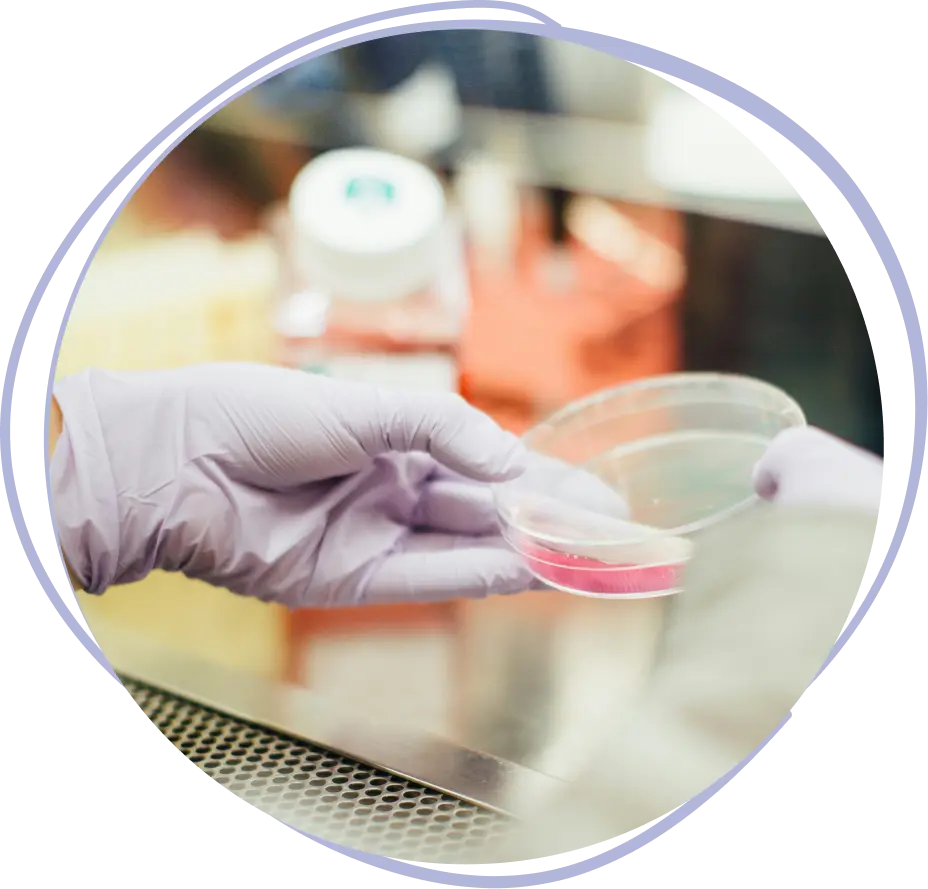

Fecundación in vitro en México
FIVET Tratamiento de fertilidad en México

¿Anhelas formar
una familia?
La fecundación in vitro (FIVET) te acerca a ese sueño.
En FertilyLife, comprendemos tu profundo deseo de ser madre. Por eso, ofrecemos un tratamiento de fecundación in vitro integral, personalizado y guiado por especialistas de primer nivel para acompañarte en cada paso del camino hacia la maternidad.
No dudes en contactarnos para conocer más sobre nuestro tratamiento de fecundación in vitro.
Contactar ahora

¿En qué consiste la fecundación in vitro?
Tu oportunidad de lograr un embarazo con éxito.
La fecundación in vitro (FIVET) es una técnica de reproducción asistida de alta complejidad que ofrece una alternativa eficaz para parejas que enfrentan dificultades para concebir de forma natural. Mediante un proceso minucioso, se extraen los óvulos de la mujer, se fecundan con los espermatozoides del hombre en un laboratorio y se transfieren los embriones resultantes al útero para lograr el embarazo.
Etapas del proceso de fecundación in vitro
Un viaje hacia la creación de tu milagro


Estimulación ovárica
Sin duda, la FIVET es la técnica más utilizada en los centros de reproducción asistida. El tratamiento de fecundación in vitro en México se realiza dentro del laboratorio y consiste en la unión de un óvulo y un espermatozoide.
¿Soy candidata para un procedimiento de fecundación in vitro en México?
Descúbrelo junto a nuestros especialistas in vitro.

Edad de la mujer

Calidad de los óvulos
y espermatozoides

Causa de la
infertilidad

Historial médico
Contáctanos ahora para agendar
una evaluación con nuestros especialistas.
Contactar ahora
Contratos
de fertilización in vitro
Transparencia y seguridad en cada paso
En FertilyLife, nos comprometemos con la transparencia y la seguridad en nuestros procesos. Te ofrecemos información clara y detallada que describe los servicios incluidos, los costos y las responsabilidades de ambas partes.
| Paquete Todo Incluido | Paquete Garantizado Gold |
|---|---|
|
1 ciclo Protocolo completo de FIV con óvulos propios |
3 ciclos Protocolo completo de FIV con óvulos propios |
|
Todas las consultas especializadas necesarias |
Todas las consultas especializadas necesarias |
|
Todos los análisis de laboratorio |
Todos los análisis de laboratorio |
|
Todos los fármacos necesarios |
Todos los fármacos necesarios |
|
Criopreservación de embriones (1 año) |
Criopreservación de embriones (1 año) |
|
Servicio de apoyo y traducción mediante asistente lingüístico |
Servicio de apoyo y traducción mediante asistente lingüístico |
Transferencia adicional de embriones con material aún disponible
(En caso de resultado negativo en el primer intento)
$ 1,800 USD
|
Paquete Todo Incluido |
Paquete |
|
$9,900 |
$26,900 |
|
*50%, previa aprobación médica |
En FertilyLife, tu tranquilidad y confianza son nuestra prioridad.
Entendemos que comenzar un tratamiento de fertilización in vitro puede generar dudas e inquietudes. Por eso, nuestro equipo de profesionales está disponible para brindarte la información y el apoyo que necesitas en cada momento.
Contáctanos para obtener más información.
Contactar
Especialistas en inseminación artificial
Tu bienestar integral es nuestro objetivo.
Sabemos que la fertilización in vitro puede ser un proceso complejo y lleno de emociones. Nuestro equipo de especialistas está aquí para acompañarte en cada paso del camino, brindándote el apoyo y la experiencia que necesitas para lograr tu sueño de formar una familia. No dudes en contactarnos para obtener más información o agendar una consulta.
¡Confía en FertilyLife, tu guía en el camino para formar una familia!
Contactar ahora